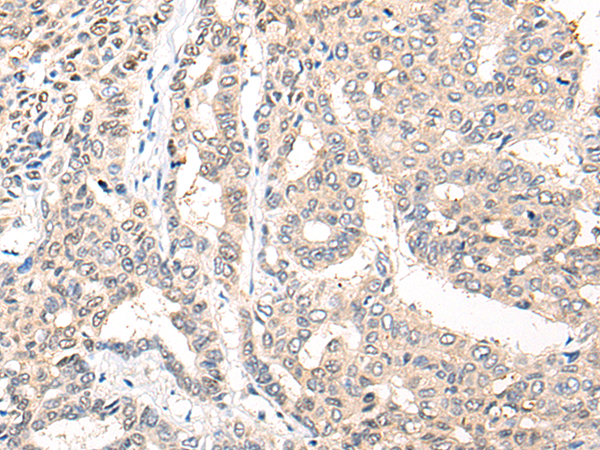
一抗

中文名稱:兔抗COL9A1多克隆抗體
|
Background: |
This gene encodes one of the three alpha chains of type IX collagen, which is a minor (5-20%) collagen component of hyaline cartilage. Type IX collagen is usually found in tissues containing type II collagen, a fibrillar collagen. Studies in knockout mice have shown that synthesis of the alpha 1 chain is essential for assembly of type IX collagen molecules, a heterotrimeric molecule, and that lack of type IX collagen is associated with early onset osteoarthritis. Mutations in this gene are associated with osteoarthritis in humans, with multiple epiphyseal dysplasia, 6, a form of chondrodysplasia, and with Stickler syndrome, a disease characterized by ophthalmic, orofacial, articular, and auditory defects. Two transcript variants that encode different isoforms have been identified for this gene. |
|
Applications: |
ELISA, IHC |
|
Name of antibody: |
COL9A1 |
|
Immunogen: |
Fusion protein of human COL9A1 |
|
Full name: |
collagen type IX alpha 1 chain |
|
Synonyms: |
MED; EDM6; STL4; DJ149L1.1.2 |
|
SwissProt: |
P20849 |
|
ELISA Recommended dilution: |
5000-10000 |
|
IHC positive control: |
Human liver cancer |
|
IHC Recommend dilution: |
25-100 |

 購(gòu)物車
購(gòu)物車 幫助
幫助
 021-54845833/15800441009
021-54845833/15800441009